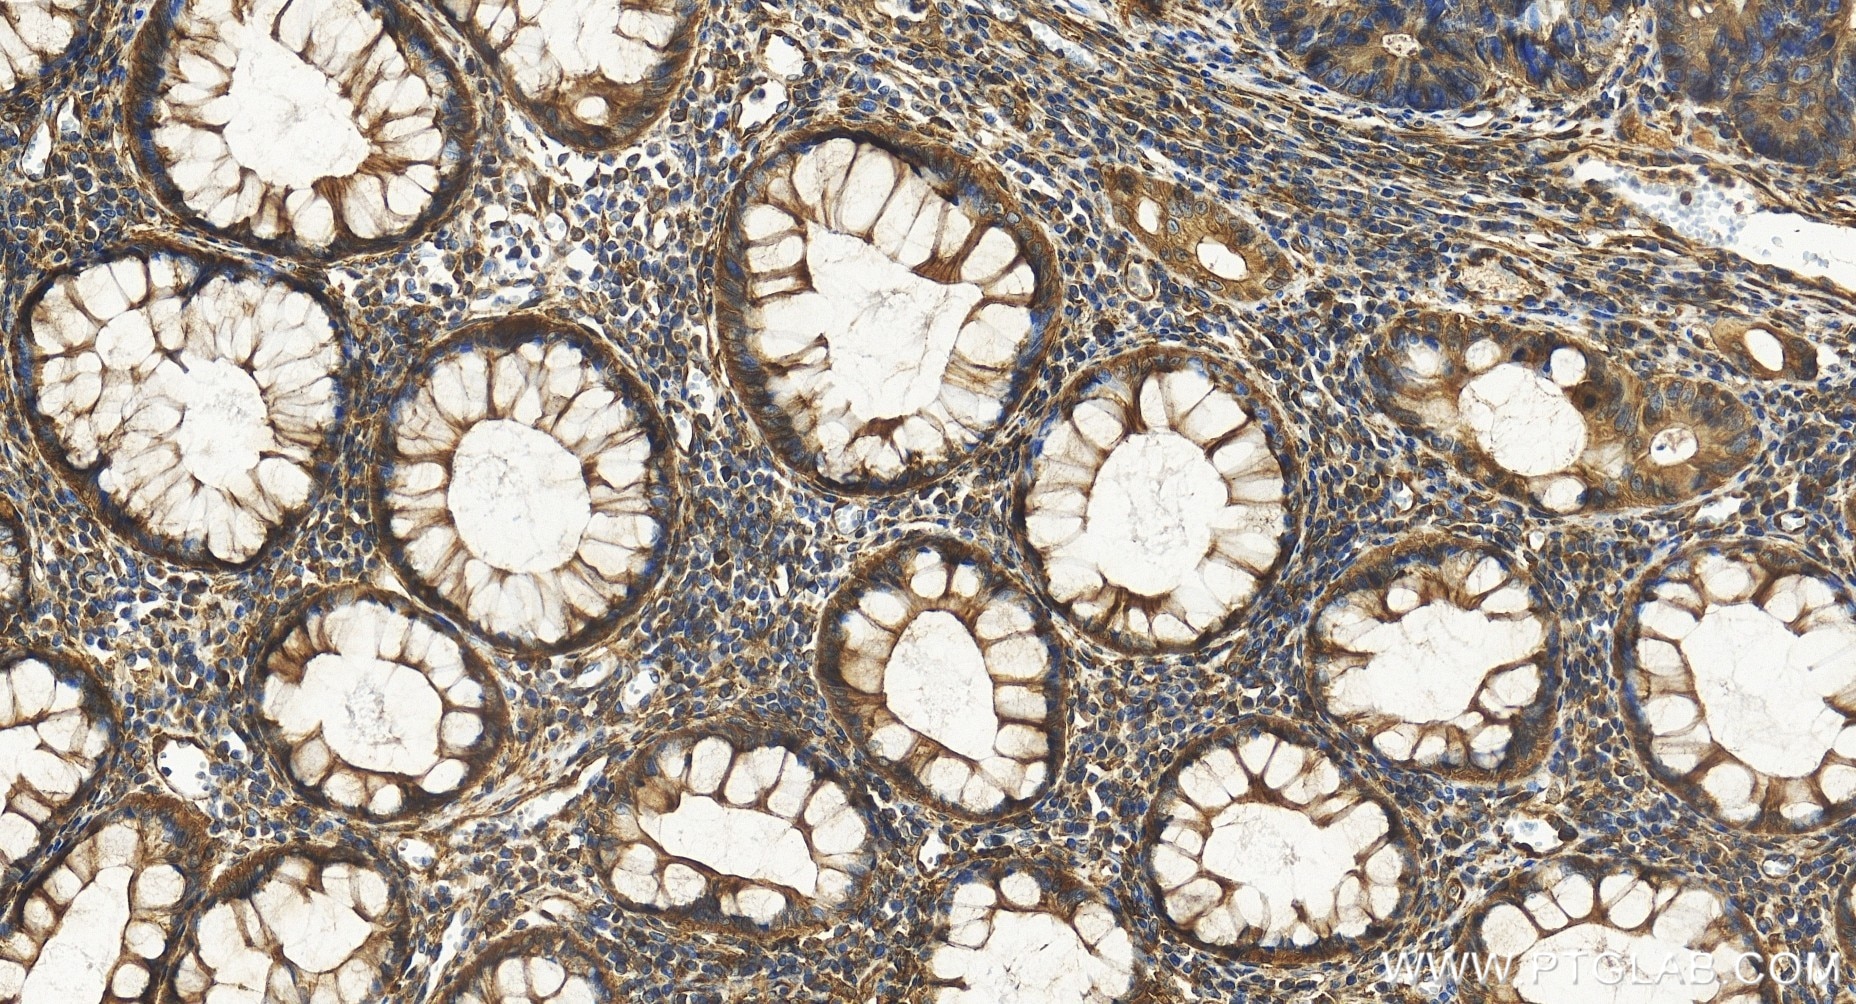
Immunohistochemical analysis of paraffin-embedded human colon cancer tissue slide using 85210-4-RR (KCTD5 antibody) at dilution of 1:500 (under 20x lens). Heat mediated antigen retrieval with Tris-EDTA buffer (pH 9.0). Immunohistochemistry (IHC) staining of human colon cancer tissue using KCTD5 Recombinant monoclonal antibody (85210-4-RR)

Validation Data Gallery
Tested Applications
| Positive IHC detected in | human ovary cancer tissue, human colon cancer tissue Note: suggested antigen retrieval with TE buffer pH 9.0; (*) Alternatively, antigen retrieval may be performed with citrate buffer pH 6.0 |
| Positive IF/ICC detected in | HeLa cells |
Recommended dilution
| Application | Dilution |
|---|---|
| Immunohistochemistry (IHC) | IHC : 1:250-1:1000 |
| Immunofluorescence (IF)/ICC | IF/ICC : 1:200-1:800 |
| It is recommended that this reagent should be titrated in each testing system to obtain optimal results. | |
| Sample-dependent, Check data in validation data gallery. | |
Product Information
85210-4-RR targets KCTD5 in IHC, IF/ICC, ELISA applications and shows reactivity with human samples.
| Tested Reactivity | human |
| Host / Isotype | Rabbit / IgG |
| Class | Recombinant |
| Type | Antibody |
| Immunogen |
CatNo: Ag7915 Product name: Recombinant human KCTD5 protein Source: e coli.-derived, PGEX-4T Tag: GST Domain: 1-234 aa of BC007314 Sequence: MAENHCELLSPARGGIGAGLGGGLCRRCSAGLGALAQRPGSVSKWVRLNVGGTYFLTTRQTLCRDPKSFLYRLCQADPDLDSDKDETGAYLIDRDPTYFGPVLNYLRHGKLVINKDLAEEGVLEEAEFYNITSLIKLVKDKIRERDSKTSQVPVKHVYRVLQCQEEELTQMVSTMSDGWKFEQLVSIGSSYNYGNEDQAEFLCVVSKELHNTPYGTASEPSEKAKILQERGSRM 相同性解析による交差性が予測される生物種 |
| Full Name | potassium channel tetramerisation domain containing 5 |
| Calculated molecular weight | 26 kDa |
| GenBank accession number | BC007314 |
| Gene Symbol | KCTD5 |
| Gene ID (NCBI) | 54442 |
| Conjugate | Unconjugated |
| Form | |
| Form | Liquid |
| Purification Method | Protein A purification |
| UNIPROT ID | Q9NXV2 |
| Storage Buffer | PBS with 0.02% sodium azide and 50% glycerol{{ptg:BufferTemp}}7.3 |
| Storage Conditions | Store at -20°C. Stable for one year after shipment. Aliquoting is unnecessary for -20oC storage. |
Background Information
KCTD5 belongs to the human potassium (K+) channel tetramerization domain (KCTD) family of proteins which share sequence similarity with the cytoplasmic domain of voltage-gated K+ channels (Kv channels). The KCTD proteins have relatively conserved N-terminal domains and variable C-termini (PMID: 24268103). KCTD5 interacts with cullin3 and has been proposed to function as substrate adapter for cullin3 based ubiquitin E3 ligases (PMID: 26188516).
Protocols
| Product Specific Protocols | |
|---|---|
| IF protocol for KCTD5 antibody 85210-4-RR | Download protocol |
| IHC protocol for KCTD5 antibody 85210-4-RR | Download protocol |
| Standard Protocols | |
|---|---|
| Click here to view our Standard Protocols |